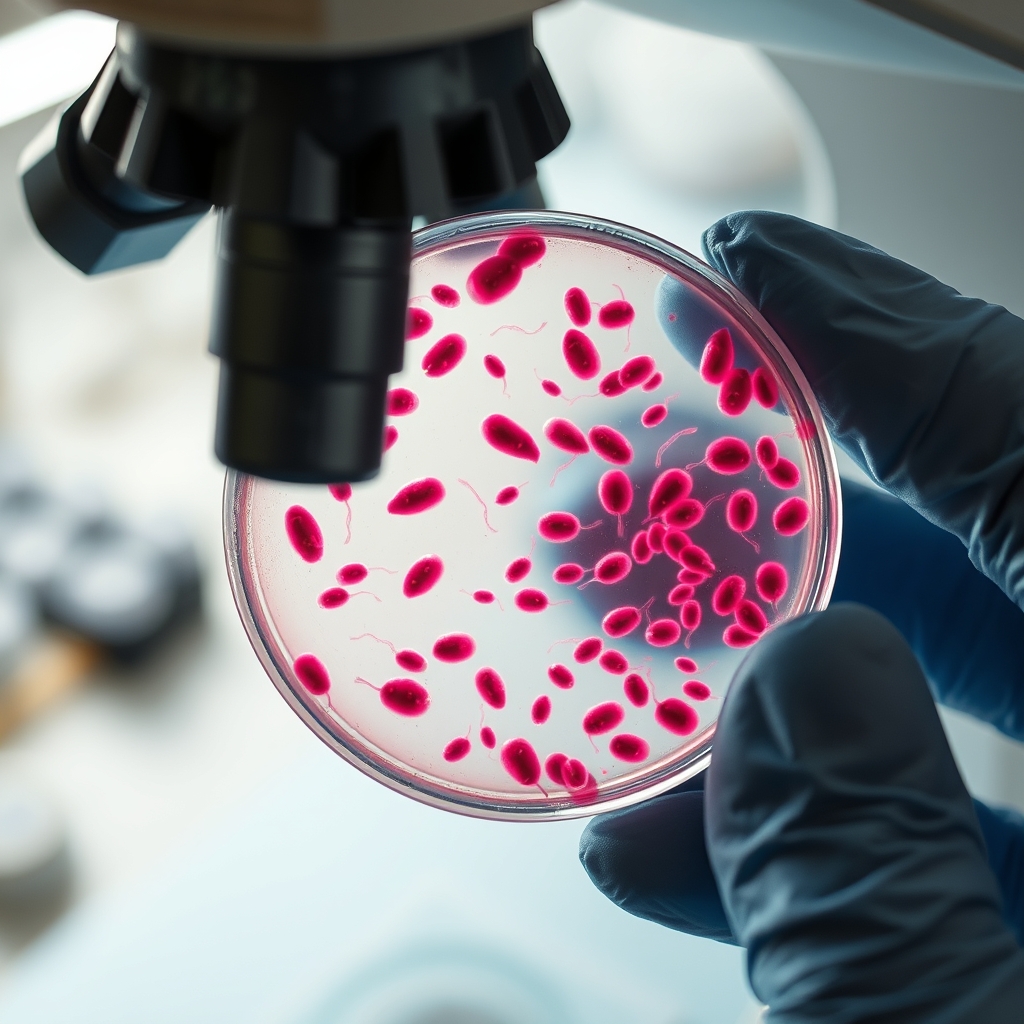
Researchers reveal the sugar-fuel switch – detailed guide & hot deals on Kadoo Click

Unlocking the hidden engine of fertilization
In a modest laboratory at Michigan State University, a team of biochemists has illuminated a long‑standing mystery of reproduction: how a seemingly dormant sperm cell erupts into a high‑velocity projectile capable of traversing the female reproductive tract. By tracing the fate of glucose molecules as they enter the tiny flagellum, the researchers mapped a cascade of enzymatic steps that transform simple sugar into a burst of kinetic energy.
The metabolic road map of a racing sperm
Using real‑time fluorescence imaging, the scientists observed that, once a sperm encounters the chemical cues of the egg's surrounding fluid, it rapidly uptakes glucose. The sugar is then funneled through the glycolytic pathway, a well‑known series of reactions that break down glucose into pyruvate while generating ATP, the cell's energy currency. What sets this process apart is its timing: a swift, multi‑step activation that mirrors the ignition of a high‑performance engine.
Why aldolase matters: a biochemical traffic controller
At the heart of the switch sits the enzyme aldolase, which cleaves a six‑carbon sugar fragment into two three‑carbon pieces, priming them for downstream energy production. "We were astonished by how a single enzymatic pivot can flip the entire metabolic state of the cell," said Dr. Emily Carter, the study's senior author. Adjacent enzymes act like traffic lights, ensuring that the flow of metabolites proceeds in a coordinated fashion rather than spiraling into wasteful by‑products.
Broader implications and the road ahead
The discovery resonates beyond reproductive biology. Similar metabolic switches have been documented in sprint‑type muscle fibers, where rapid ATP generation powers brief, explosive movements, and in certain cancer cells that hijack glycolysis for unchecked growth. By contrasting these systems, the researchers argue that nature repeatedly repurposes a core biochemical toolkit for very different physiological challenges.
From a reporting perspective, the study underscores how a granular view of cellular chemistry can reshape our understanding of macro‑level phenomena such as fertility. While the work is still in its early stages, it opens the door to potential diagnostic tools that assess sperm metabolic vigor, a factor that traditional semen analyses often overlook.